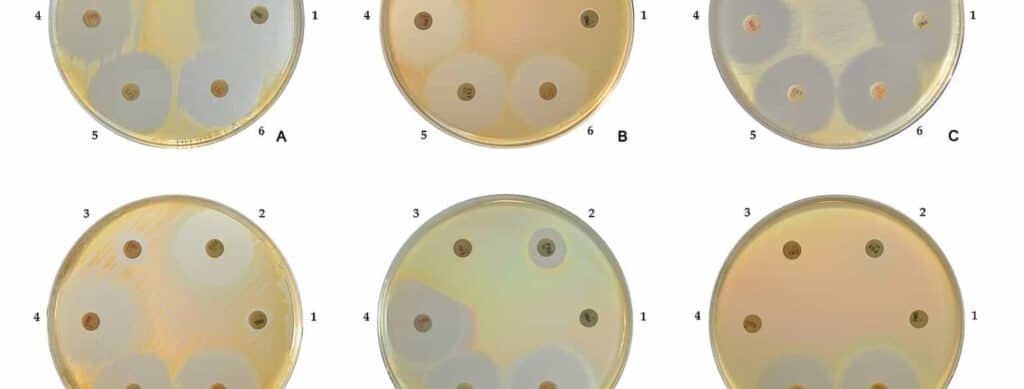

Ten years ago, if you asked someone to describe artificial intelligence, they would have probably referenced Ironman’s trusty sidekick J.A.R.V.I.S or the self-aware and malevolent Skynet from Terminator. Fast forward to today, AI is no longer confined to movies or science fiction novels. They have seamlessly woven into our lives, sometimes as a voice assistant that plays your favourite songs on demand, the grammar checker that refines your emails, or the advanced algorithm that predicts new drug compounds from a pool of molecular possibilities larger than the number of stars in our Milky Way galaxy.
In this article, we will explore how the emergence of AI can speed up drug and diagnostic discovery processes and how these advances could be the key to combating the rapid rise of the global public threat of Antimicrobial Resistance or AMR.

Source: Generated using AI
AI aids faster drug discovery
The journey of a drug that one buys from a pharmacy begins at a research laboratory, where scientists first need to identify a target for the drug to act on. The target could be a protein or a biological pathway in our body that is associated with a certain disease or condition. The drug molecule’s job is to swoop in and block the disease-related protein or pathway, thus preventing the progression of the disease. Once the target is identified, the search begins for molecules that can affect the target by testing over 10,000 possible drug-like molecules.

Source: The Pharmaceutical Journal, PJ March 2015 online, online URL: 20068196
A similar tedious process also applies to the development of diagnostic tools, which hinge on the identification of biological markers associated with diseases, such as elevated levels of specific chemicals in the blood, genetic mutations in body tissues, or the presence of abnormal growths in organs. This is followed by identifying techniques that can help detect these biomarkers.
The processes mentioned above are merely the beginning of the drug and diagnostic discovery pipeline; they involve years of laboratory work and clinical trials, all of which require significant financial investments. Fortunately, AI approaches can reduce the time spent looking for drug targets to a few months.
To ensure that AI models make informed predictions and decisions, they are trained on a wide spectrum of data involved with the specific process. In drug discovery, the training data often includes the chemical properties of drug-like molecules, their structures, toxicity profiles, findings from animal studies, and outcomes from human clinical trials, among other details. For diagnostics development, the training dataset might include results from blood tests, genomic sequencing data, or MRI, CT-Scan or X-ray images, depending on the type of diagnostic tool being developed.
This data, collected by researchers or pharmaceutical companies over decades of research, is then processed with the help of machine learning, a type of computer algorithm that can pick up patterns in data. The AI learns to identify the key points required to identify potential drug-like molecules or diagnostic tools.
AI meets AMR Research
Ever since the discovery of penicillin by Alexander Fleming in 1928, antibiotics have been humanity’s ally in the battle against deadly bacterial infections. Their success, however, turned them into a go-to remedy for various diseases, regardless of their nature. This overuse and misuse of antibiotics resulted in the emergence of ‘Superbugs’ —bacteria that have evolved to develop resistance against drugs designed to kill them. This phenomenon, known as AMR, is a global concern that is on the rise, affecting millions of lives every year.
Antibiotic resistant bacteria aren’t a new thing but their effect was easily countered by a steady flow of new antibiotics that the bacteria hadn’t developed resistance to. The situation, however, changed post 1980s as we started running out of new classes of antibiotics due to a ‘discovery void’ owing to the practical challenges of drug discovery.

Source: ReAct
To prevent the AMR problem from getting any worse, there is an urgent need for developing new classes of antibiotics that are effective against drug resistant bacteria. But drugs alone cannot combat this issue; we also need diagnostic tools that can identify bacterial infections, ensuring the correct use of antibiotics and tests that can detect antibiotic resistant infections to help doctors select the right treatment plans.
The evolution of AI technology has brought a beacon of hope, as scientists are able to harness the power of AI to boost AMR-related research. Here are some noteworthy developments in this field:
1) AI helps scientists identify a new class of antibiotic candidates after 60 years
MRSA, or methicillin-resistant Staphylococcus aureus, is a type of bacteria that has developed resistance to multiple antibiotics. It can cause skin infections, pneumonia, hospital acquired bloodstream infections, and surgical site infections. If not treated, MRSA infections can also turn into life-threatening sepsis, where the immune system overreacts, causing damage to organs and tissues. According to a CDC report, MRSA is responsible for over 120,000 bloodstream infections and 20,000 associated deaths in the United States alone.
Researchers from Harvard University and MIT used AI to discover a new class of antibiotics to deal with MRSA. The AI algorithm evaluated 39,000 drug-like molecules for their antibiotic activity against MRSA and emerged with the best possible options. The researchers then tested 283 of those possibilities and were able to identify two promising antibiotic candidates from the same class. One is effective against hard-to-kill MRSA and the other against stubborn vancomycin-resistant enterococci, a type of bacteria that has developed resistance to vancomycin, a drug commonly used to treat antibiotic-resistant infections.

Scanning electron micrograph of methicillin-resistant Staphylococcus aureus (MRSA, yellow) surrounded by cellular debris. Source: Flickr. Credit: NIAID
2) AI models that can detect AMR in just 30 minutes
Antibiotic susceptibility testing or AST, is performed to determine the effectiveness of a specific antibiotic in killing certain bacteria and to identify if bacteria have developed resistance to certain antibiotics. The AST test results can help doctors decide the right plan to treat bacterial infections. While there are many highly efficient AST methods at our disposal, it takes at least 18-24 hours to get back the results.
Determination of resistance of Staphylococcus aureus to a number of widely used antibiotics. Source: Store Norske Leksikon Credit: HansN.
Researchers from the University of Oxford developed an AI-based rapid AST capable of detecting antibiotic resistance within 30 minutes. This technique uses a deep learning model, a type of AI, to process a database of bacterial cell images and analyse the changes that occur when being treated with antibiotics. For instance, when an antibiotic is effective, it stops bacterial growth by causing structural changes in the bacterial cells, whereas when ineffective antibiotics are used, no such changes can be observed.
Utilising this information, the deep learning model was able to detect cases of antibiotic resistance for multiple antibiotics with 80% accuracy and at a speed 10 times faster than established clinical methods.
3) AI rapidly identifies pneumonia-causing bacteria in Emergency Rooms
Over the last few decades, the emergence of multidrug resistant bacteria has made the management of pneumonia cases very challenging and the number of pneumonia patients requiring intensive care has also seen a significant rise.
A team of scientists demonstrated that AI could come to the rescue of healthcare professionals by predicting the type of bacteria that are causing pneumonia in patients by using medical data available in emergency rooms.
They collected over 50,000 hospital records of patients admitted to the ICU and trained the AI on records of patients who were admitted for pneumonia. The AI was then able to identify if the patient was suffering from an MRSA or Pseudomonas infection. Thus allowing doctors to prescribe the right antibiotics aimed at the particular bacteria.
With AI gaining new abilities every other day, it is on the brink of revolutionising our approach to combating AMR and saving countless lives. It’s a battle of Supercomputers versus Superbugs.